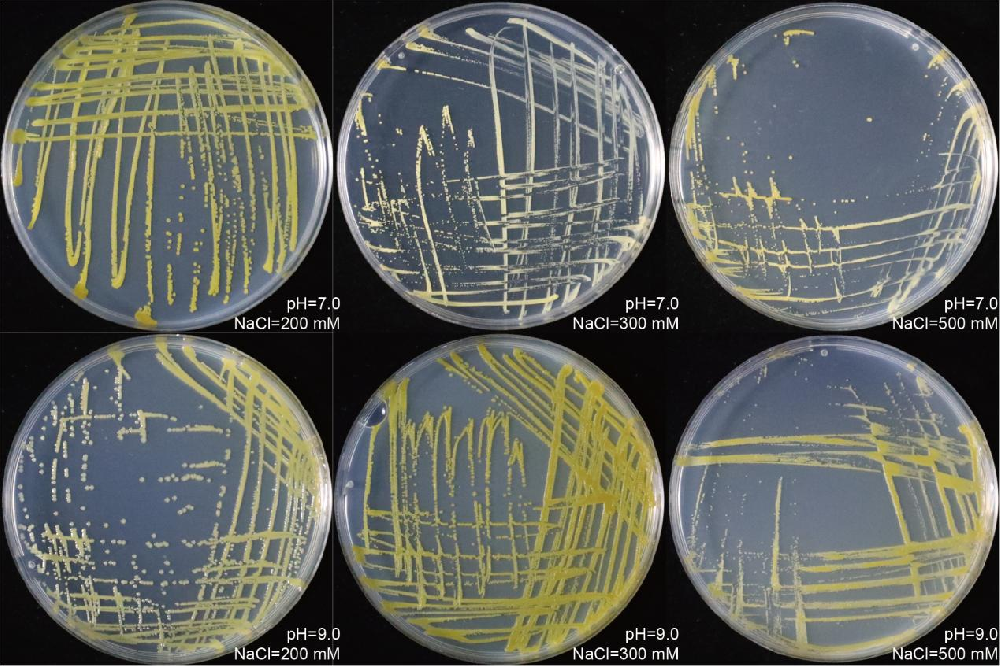
7cbe6ba4ae11cf02aa6c5d83469e2557.png

一、成果简介
本成果从野生大豆中分离筛选出一株嗜冷假单胞菌77S3(CCTCC M 2023852),为大豆内生耐盐碱功能菌株。该菌株可显著提高大豆在盐胁迫环境下的耐盐性与生长势,兼具解磷、产IAA双重促生功能,可制成液体/固体菌剂,通过浸种、拌土、灌根、喷施等方式应用,从根本上解决盐碱地大豆出苗差、长势弱、产量低的问题,是盐碱地大豆绿色增产的原创微生物技术。
二、成果创新点及技术优势
①专属耐盐碱功能菌株:首次获得大豆内源嗜冷假单胞菌77S3,高耐盐(可耐受500mM NaCl)、耐高碱(pH=9.0),盐碱环境下存活与定殖能力突出(图1)。
图1. Pseudomonas sp. 77S3在500 mM NaCl、pH 9.0的极端条件下表现出稳定生长能力。(Plant Biotechnol. J., 2025)
②盐胁迫下显著增产:150mM盐胁迫下,可使大豆株高增加16.29%、根长增加15.73%、根鲜重增加20.77%、根干重增加24.14%,长势显著提升。
③天然内生菌,不污染土壤与作物,替代化学改良剂,符合绿色农业与盐碱地改良政策。
值得关注的是,该菌株发酵冻干菌粉在4℃长期储存后仍保持高活力,其新鲜菌液与发酵冻干制剂均能显著提升大豆耐盐性(图2),表现出突出的稳定性与应用潜力,在盐碱地大豆种植中具有广阔的推广前景。

图2. Pseudomonas sp. 77S3发酵冻干菌粉处理显著增强了大豆对盐胁迫的耐受性(Plant Biotechnol. J., 2025)
三、应用领域
属农业技术领域,成果转化目标客户为微生物肥料企业、大豆育种单位、盐碱地改良机构、规模化大豆种植基地、旱作与盐渍化农田治理服务商。
四、专利信息
专利名称:嗜冷假单胞菌 77S3、菌剂及其应用
专利号:ZL202310918701.2
申请日:2023年07月25日
授权日:2025年02月11日
发明人:罗晓、张婉莹、田健玮、方义生
专利权人:北京大学现代农业研究院
五、成果转化方式:
许可或转让,费用协商确定。
六、联系方式:
转化手续办理咨询:于欣鑫,0536-6030888
技术咨询:罗晓,xiao.luo@pku-iaas.edu.cn